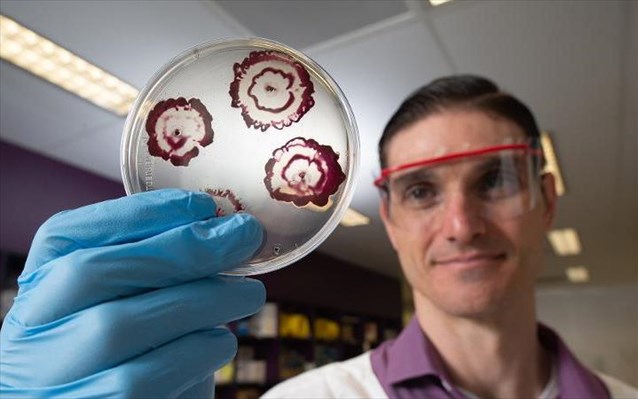

Πολλά υποσχόμενη ως προς την αντιμετώπιση επικίνδυνων μολύνσεων σταφυλόκοκκου εμφανίζεται μια νέα γενιά αντιβιοτικών που αναπτύσσουν ερευνητές του Queensland University of Technology (QUT).
Τα βακτήρια προσκολλώνται σε ιατρικές συσκευές, μεταξύ των οποίων καθετήρες, τεχνητές αρθρώσεις, εμφυτεύματα κ.α., δημιουργώντας βακτηριακά βιοφίλμ (μεμβράνες), που αποτελούν σημαντικό παράγοντα αποτυχίας θεραπειών με αντιβιοτικά και χρόνιων μολύνσεων.
Οι ερευνητές του QUT ανέπτυξαν υβριδικά αντιβιοτικά, ειδικά σχεδιασμένα για να διαπερνούν την κολλώδη «ασπίδα» που προστατεύει τις μολύνσεις με «χρυσό» σταφυλόκοκκο (Staphylococcus aureus).
Η έρευνα, της οποίας ηγήθηκαν μια Ελληνίδα επιστήμονας, η αναπληρώτρια καθηγήτρια Μακρίνα Τότσικα, και ο διδακτορικός φοιτητής Άντονι Βερντερόσα, δημοσιεύτηκε στο Antimicrobial Agents and Chemotherapy. Στο πλαίσιό της διαπιστώθηκε πως τα υβριδικά αντιβιοτικά ήταν αποτελεσματικά στην καταστροφή βιοφίλμ σταφυλόκοκκου που είχα καλλιεργηθεί στο εργαστήριο.
«Τα βιοφίλμ είναι μια κολλώδης, γλοιώδης επικάλυψη που συχνά εμποδίζει τα συμβατικά αντιβιοτικά να έχουν πρόσβαση σε βακτηριακά κύτταρα» είπε ο Βερντερόσα. «Αναπτύξαμε μια νέα γενιά αντιβιοτικού που ξεγελά τα βιοφίλμ, έτσι ώστε να απελευθερώσουν τα προστατευμένα τους κύτταρα, επιτρέποντας πρόσβαση διαμέσου της προστατευτικής γλοιώδους επικάλυψης του βιοφίλμ. Αυτό επιτρέπει την εξάλειψη των βιοφίλμ».
Όπως είπε, το μείγμα εκπέμπει ένα φθορίζον σήμα που επιτρέπει στους ερευνητές να παρακολουθούν το φάρμακο να διαπερνά το βιοφίλμ, είτε σκοτώνοτνας απευθείας τα βακτηρίδια είτε αφήνοντάς τα ευάλωτα.
Η Δρ. Τότσικα είπε πως η πλειονότητα των μολύνσεων, ακόμα και αυτών που δεν σχετίζονται με εμφυτευμένες ιατρικές συσκευές, περιλαμβάνουν βιοφίλμ με κάποιον τρόπο, οπότε το εύρος δυνατοτήτων αυτών των φαρμάκων είναι πολύ μεγάλο. «Αυτό που είναι πολλά υποσχόμενο είναι πως οι ενώσεις μας είναι υβρίδια φαρμάκων που είναι ήδη σε κλινική χρήση, ως μεμονωμένες θεραπείες…οπότε αυτό μας κάνει να ελπίζουμε ότι θα μπορούσαν να “μεταφραστούν” σε κλινικές θεραπείες στο όχι και τόσο μακρινό μέλλον».